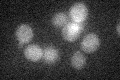
YIL106W
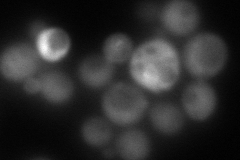
YIL106W
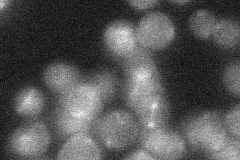
YIL106W
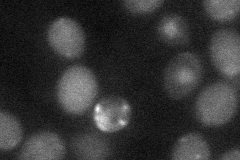
YIL106W
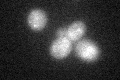
YIL106W

View description
Component of the mitotic exit network; associates with and is required for the activation and Cdc15p-dependent phosphorylation of the Dbf2p kinase; required for cytokinesis and cell separation; component of the CCR4 transcriptional complex
Localization:
Intensity:
Fold change:
Significance:
-
C’ GFP library in SD
below threshold13.36 -
N' NOP1pr-GFP in SD

cytosol,punctate49.6757 -
N' TEF2pr-mCherry in SD
cytosol,punctate27.0775 -
N' NATIVEpr-GFP in SD
below threshold19.1978 -
N' TEF2pr-VC and Cyto-VN in SD
cytosol30.7119 -
C’ GFP library in SD+DTT
cytosol15.551.16No -
C’ GFP library in SD+H2O2

cytosol17.551.31No -
C’ GFP library in Starvation Media

cytosol20.711.54No -
C’ GFP library on the background of Pup2-DaMP

below threshold -
C’ GFP library on the background of CCT mutant

below threshold16.44631.23033No
